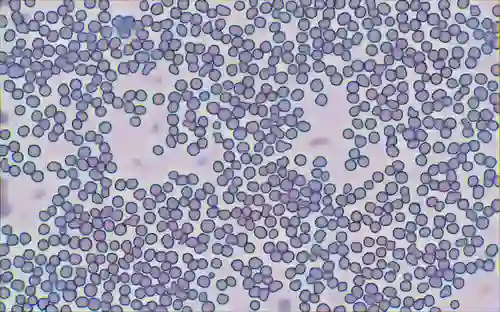

In this paper, we describe how to apply image-to-image translation techniques to medical blood smear data to generate new data samples and meaningfully increase small datasets. Specifically, given the segmentation mask of the microscopy image, we are able to generate photorealistic images of blood cells which are further used alongside real data during the network training for segmentation and object detection tasks. This image data generation approach is based on conditional generative adversarial networks which have proven capabilities to high-quality image synthesis. In addition to synthesizing blood images, we synthesize segmentation mask as well which leads to a diverse variety of generated samples. The effectiveness of the technique is thoroughly analyzed and quantified through a number of experiments on a manually collected and annotated dataset of blood smear taken under a microscope.
翻译:在本文中,我们描述如何将图像到图像翻译技术应用于医学血液涂片数据,以生成新的数据样本,并有意义地增加小数据集。具体地说,鉴于显微镜图像的分解面罩,我们能够产生出血细胞的光真化图像,在进行分解和物体探测任务网络培训期间,这些图像与真实数据一起进一步使用。这种图像数据生成方法以有条件的基因化对抗网络为基础,这些网络已证明具有高质量图像合成能力。除了将血液图像合成外,我们还合成了分解面罩,并导致产生各种样本。通过对在显微镜下人工收集的和附加说明的血清数据集进行一系列实验,对技术的有效性进行了彻底分析和量化。